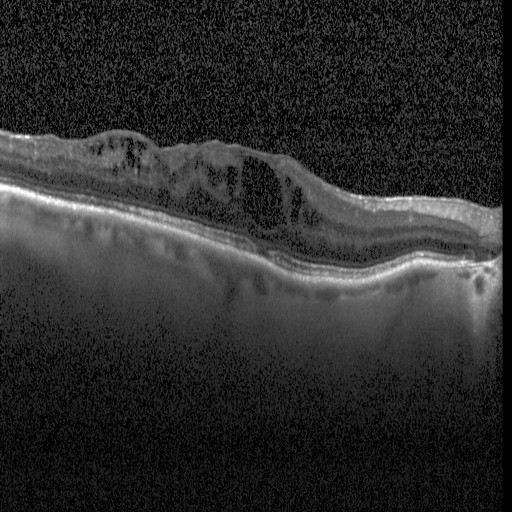
VitalVantage – screenshot 1

Inspiration
Our friends had bad experiences in the ER recently because they were forced to wait, while in urgent condition, for a long time. They weren't able to get some of the care that they needed.
What it does
It bridges the gap between doctor and patient and makes the healthcare system more productive.
How we built it
We used pytorch to make a CNN that detects eye diseases. VitalVantage will eventually be able to take all sorts of scans and diagnose patients. However, for now it focuses on eye diseases as a proof of concept. It also takes in patient vitals like BPM, Sleep Quality, BMI, Blood Pressure, and Cholesterol.
Challenges we ran into
We had issues with the Apple Health API so we had to switch to FitBit's API as our mode of taking patient vitals.
Accomplishments that we're proud of
We are proud of the accuracy of our CNN and its integration into our website.
What we learned
We learned a lot about how to properly work as a team on github and organize code well.
What's next for VitalVantage
It will take more than just eye diseases. It will also give recommendations and help book doctors appointments.
Log in or sign up for Devpost to join the conversation.